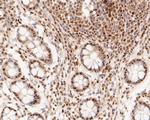
MTA2 Antibody in Immunohistochemistry (Paraffin) (IHC (P))

Search
Invitrogen
MTA2 Monoclonal Antibody (17A1)
{{$productOrderCtrl.translations['antibody.pdp.commerceCard.promotion.promotions']}}
{{$productOrderCtrl.translations['antibody.pdp.commerceCard.promotion.viewpromo']}}
{{$productOrderCtrl.translations['antibody.pdp.commerceCard.promotion.promocode']}}: {{promo.promoCode}} {{promo.promoTitle}} {{promo.promoDescription}}. {{$productOrderCtrl.translations['antibody.pdp.commerceCard.promotion.learnmore']}}
图: 1 / 8
MTA2 Antibody (MA5-34950) in IHC (P)

Please note: We are reviewing Western blot images included in the antibody testing data in our catalog, including those provided by third parties. Unless expressly labeled or annotated as “raw-unedited”, Western blot images included in the antibody testing data in our catalog may have been edited, optimized or otherwise adjusted for presentation.
产品信息
MA5-34950
种属反应
宿主/亚型
分类
类型
克隆号
抗原
偶联物
形式
浓度
规格
纯化类型
保存液
内含物
保存条件
运输条件
RRID
产品详细信息
Positive Control: K562, MCF-7, SH-SY5Y, Daudi, human colon carcinoma tissue, human skin tissue, human breast tissue, human breast carcinoma tissue, human gastric carcinoma tissue, human small intestine tissue.
靶标信息
This gene encodes a protein that has been identified as a component of NuRD, a nucleosome remodeling deacetylase complex identified in the nucleus of human cells. It shows a very broad expression pattern and is strongly expressed in many tissues. It may represent one member of a small gene family that encode different but related proteins involved either directly or indirectly in transcriptional regulation. Their indirect effects on transcriptional regulation may include chromatin remodeling. It is closely related to another member of this family, a protein that has been correlated with the metastatic potential of certain carcinomas. These two proteins are so closely related that they share the same types of domains. These domains include two DNA binding domains, a dimerization domain, and a domain commonly found in proteins that methylate DNA. One of the proteins known to be a target protein for this gene product is p53. Deacetylation of p53 is correlated with a loss of growth inhibition in transformed cells supporting a connection between these gene family members and metastasis.
仅用于科研。不用于诊断过程。未经明确授权不得转售。
篇参考文献 (0)
生物信息学
蛋白别名: DKFZp686F2281; Metastasis-associated 1-like 1; Metastasis-associated protein MTA2; MTA1-L1 protein; p53 target protein in deacetylase complex
基因别名: MTA1L1; MTA2; PID
Entrez Gene ID: (Human) 9219




